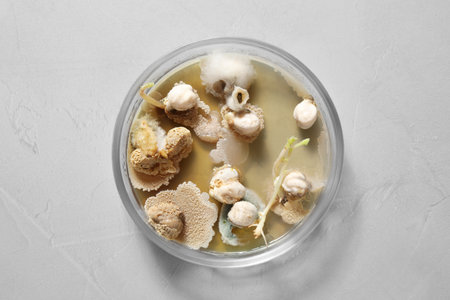
Germination and energy analysis of chickpeas in Petri dish on light table, top view. laboratory researchの写真素材

写真素材 - Germination and energy analysis of chickpeas in Petri dish on light table, top view. laboratory research
作品情報
Germination and energy analysis of chickpeas in Petri dish on light table, top view. laboratory research
- ID:210289841
- 作品種別:写真
- 作者名:liudmilachernetska
キーワード
- agricultural
- agriculture
- agronomy
- analysis
- analyzing
- background
- bio
- biochemistry
- biology
- biotech
- biotechnology
- botany
- chemistry
- chickpea
- chickpeas
- dish
- energy
- examination
- experiment
- farming
- germination
- glass
- glassware
- gmo
- industry
- lab
- laboratory
- light
- mold
- natural
- object
- organic
- petri
- research
- science
- scientific
- seeds
- stone
- table
- test
- top
- view
類似作品
Fresh micro gre...
Pea seeds sprou...
Sprouted chickp...
Bean sprout on ...
Modern Laborato...
Close-up of pea...
Chemical Labora...
Samples in box ...
Laboratory for ...
Sprouted green ...
Sprouted peas o...
Fresh micro gre...
sprouts of peas...
Fast growing pe...
Roots of micro ...
Fresh micro gre...
Fresh micro gre...
Fresh micro gre...
healthy food. c...
Fresh micro gre...
Mung bean sprou...
Pea sprouts on ...
Science, chemis...
Sprouted Kala C...
Fast growing pe...
Fast growing pe...
Sprouted grains...
Sprouted Kala C...
Chemical Labora...
Sprouted Kala C...
Fresh micro gre...
High angle seed...
Sprouted Kala C...
Fresh micro gre...
Three sprouted ...
Chickpeas, whit...
Roots of micro ...
A pieces of tru...
A picture of sa...
Roots of micro ...
Home gardening....
grapeseed essen...
Roots of micro ...
Sprouted chickp...
Female hand hol...
Woman hand hold...
Microgreens, ge...
Samples in box ...
Samples in box ...